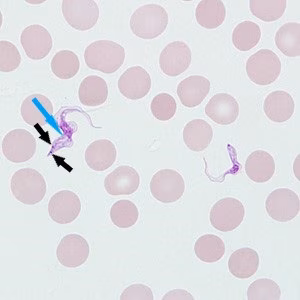
Case_514_B_Answer Case_514_answer

Case #514 – April, 2020
A 24-year-old female exchange student from Guinea reported to the clinic with headaches, itchy skin, and enlarged lymph nodes. She recalled multiple painful insect bites in her country prior to her travel to the United States. A rapid diagnostic test for malaria performed at the clinic was negative. Smears were subsequently made and stained with Wright-Giemsa. Figures A and B show what was observed on a thin blood smear at 1000x oil magnification. What is your diagnosis? Based on what criteria?

Figure A

Figure B
Images presented in the dpdx case studies are from specimens submitted for diagnosis or archiving. On rare occasions, clinical histories given may be partly fictitious.
DPDx is an educational resource designed for health professionals and laboratory scientists. For an overview including prevention, control, and treatment visit www.cdc.gov/parasites/.